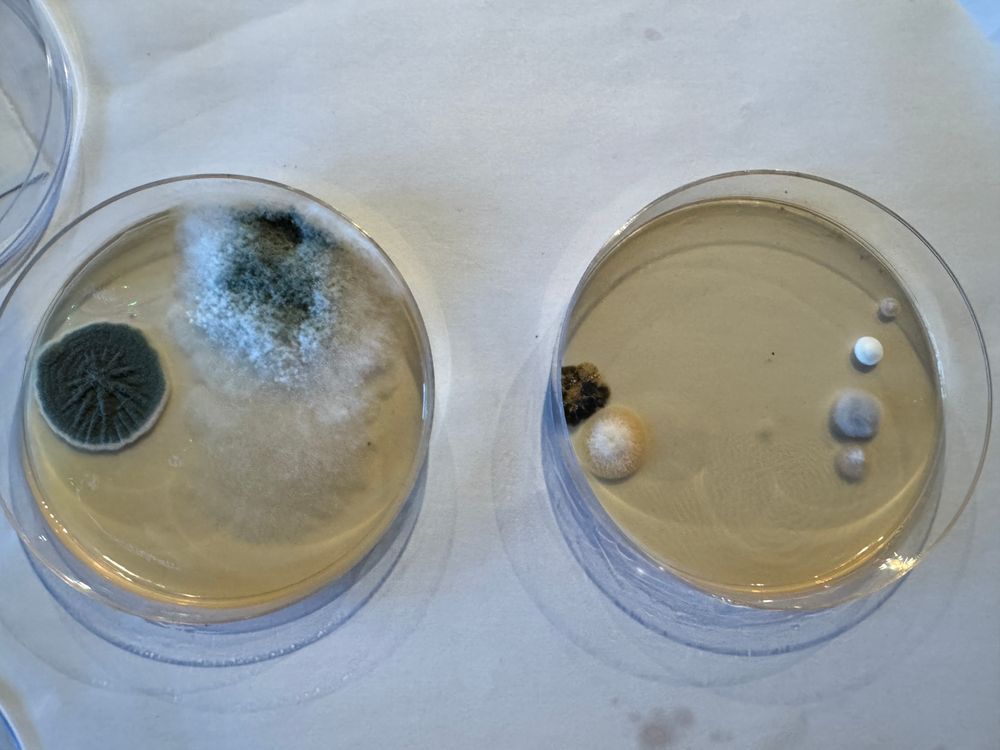
Petri dish air samples: ‘Bathroom sample’ vs. ‘Outside control sample’. Airborne mold in the home—documented evidence.

New federal judge filing just gave us roadmap to proceed
But most attorneys are scared to sue government in Trump 2.0
New federal judge filing just gave us roadmap to proceed
But most attorneys are scared to sue government in Trump 2.0
We’re not just making noise, we’re making a roadmap
DM if you're a movement attorney or tag an attorney who's brave enough fight with us
📎 fundrazr.com/tap-martin-b...
#CivilRights

We’re not just making noise, we’re making a roadmap
DM if you're a movement attorney or tag an attorney who's brave enough fight with us
📎 fundrazr.com/tap-martin-b...
#CivilRights
I need healthcare, shelter, and runway to fight this case
Because I'm NOT giving up. The law is on our side. We just have to FIGHT
WHO WILL FIGHT WITH ME?

I need healthcare, shelter, and runway to fight this case
Because I'm NOT giving up. The law is on our side. We just have to FIGHT
WHO WILL FIGHT WITH ME?
At minimum, I need limited scope representation (administrative only) so I can accept funding and stop hemorrhaging
But long-term, I need co-counsel who are FIGHTERS
At minimum, I need limited scope representation (administrative only) so I can accept funding and stop hemorrhaging
But long-term, I need co-counsel who are FIGHTERS
@aclu.org was stuck in court. I bypassed the broken system entirely
I'm a creative technologist. I build tools to fight. And I win
medium.com/an-injustice...

@aclu.org was stuck in court. I bypassed the broken system entirely
I'm a creative technologist. I build tools to fight. And I win
medium.com/an-injustice...
Kern County law enforcement ignores penal code violations on police report
CalVCB rejected victim aid, and AG Bonta won't uphold his own directives
Kern County law enforcement ignores penal code violations on police report
CalVCB rejected victim aid, and AG Bonta won't uphold his own directives
They were put on notice—now I’m delivering on that promise
📎 paragraph.com/@felicelazae...

They were put on notice—now I’m delivering on that promise
📎 paragraph.com/@felicelazae...
New federal judge filing just gave us roadmap to proceed
But most attorneys are scared to sue government in Trump 2.0
New federal judge filing just gave us roadmap to proceed
But most attorneys are scared to sue government in Trump 2.0
Need: Bridge funding for housing/medicine so we can survive and finish the case. RTs help!
fundrazr.com/tap-martin-b...
Need: Bridge funding for housing/medicine so we can survive and finish the case. RTs help!
fundrazr.com/tap-martin-b...
If you can help, share, or offer advice: fundrazr.com/tap-martin-b...
If you believe housing is a human right, please share
We’re building so no one else has to beg after being abandoned
#HousingJustice #TenantRights #MutualAid

If you can help, share, or offer advice: fundrazr.com/tap-martin-b...
If you believe housing is a human right, please share
We’re building so no one else has to beg after being abandoned
#HousingJustice #TenantRights #MutualAid
We uploaded court docs to Arweave via ArDrive. No PACER fees. Permanent. No gatekeepers.
Decentralized public infrastructure is how we fight systems that abandon people.
Court docs:
app.ardrive.io#/drives/295e...
Verify on Justia/PACER: dockets.justia.com/docket/calif...

We uploaded court docs to Arweave via ArDrive. No PACER fees. Permanent. No gatekeepers.
Decentralized public infrastructure is how we fight systems that abandon people.
Court docs:
app.ardrive.io#/drives/295e...
Verify on Justia/PACER: dockets.justia.com/docket/calif...
Everything we own is locked inside
Burned through savings. Couch surfed May-Oct, now navigating precarious temporary housing again
Everything we own is locked inside
Burned through savings. Couch surfed May-Oct, now navigating precarious temporary housing again
- Visible mold samples (petri dishes showing massive growth in hours)
- Federal court docket (public record)
- 300 days police obstruction documented
- Mold pneumonia diagnosis + mycotoxin poisoning
- Service provider reports: suspected extensive mold behind walls



- Visible mold samples (petri dishes showing massive growth in hours)
- Federal court docket (public record)
- 300 days police obstruction documented
- Mold pneumonia diagnosis + mycotoxin poisoning
- Service provider reports: suspected extensive mold behind walls
Win or lose, we were HERE.
We FOUGHT.
We didn't disappear.
This is mutual aid meeting sovereignty.
This is why decentralization matters.
This is Liberation.
#DeFi #MutualAid #LiberationDAO
Win or lose, we were HERE.
We FOUGHT.
We didn't disappear.
This is mutual aid meeting sovereignty.
This is why decentralization matters.
This is Liberation.
#DeFi #MutualAid #LiberationDAO

